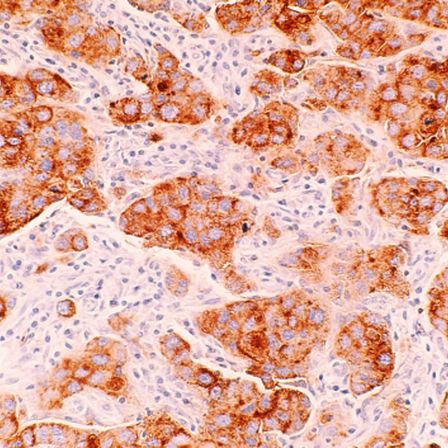

About breast cancer.
Your questions answered.

Breast cancer: what it is, what causes it, and what you can do.
Breast cancer doesn’t have one single cause. Your genes, your environment, and your everyday choices all play a role in your breast cancer risk. While some factors are out of your control, others are within your power to change.
In this section, you’ll find clear answers to the questions people ask most:
- What is breast cancer?
- Common myths, answered.
- Why acting now to reduce your risk matters.
Knowledge is the first step to prevention, and we’re here to make it clear and actionable. Think of this as your go-to guide for making sense of breast cancer, straightforward and designed to help you stay informed, not overwhelmed.
Quick facts.
Around 56,000 women and 400 men are diagnosed yearly in the UK.
Estimated lifetime risk: 1 in 7 women; 1 in 870 men.
At least 30% of breast cancers can be prevented.
Further resources.

Please select a campaign to connect this plugin with.